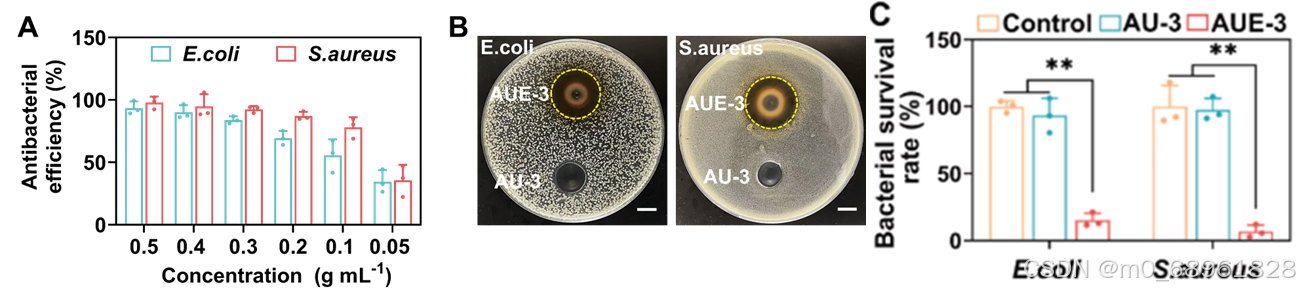

超分子水凝胶探秘,分层策略优,修复有希望
大家好!今天来了解一种高性能组织粘附水凝胶的研究——《A supramolecular hydrogel leveraging hierarchical multi-strength hydrogen-bonds hinged strategy achieving a striking adhesive-mechanical balance》发表于《Bioactive Materials》。在组织修复领域,生物粘合剂的性能至关重要。然而,现有材料如合成聚丙烯酸及其衍生物存在诸多不足,水下粘附性差、易漏液、难以平衡机械与粘附性能,还可能导致二次损伤和疤痕。本文介绍的研究致力于解决这些问题,通过制备一种新型超分子水凝胶,采用分层多强度氢键铰链策略,为实现优异的机械完整性和强大的组织粘附性之间的平衡提供了新的思路和方法。
*本文只做阅读笔记分享*

一、研究背景
在组织修复领域,生物粘合剂与组织表面建立良好生物界面至关重要,但面临诸多挑战。合成聚丙烯酸(PAAc)及其衍生物虽有一定优势,但存在水下粘附性差、易漏液、易造成二次损伤和疤痕等问题,且在平衡机械性能和粘附性能上存在困难。
二、AUE水凝胶的合成
HEA-UPy单体在AAc/HEA-UPy水溶液中发生液-液相分离,在光引发剂作用下原位共聚形成AU-x超分子水凝胶,掺入EGCG分子后得到AUE-x水凝胶。AUE水凝胶具有多种氢键交联,包括UPy-UPy、COOH-COOH、urethane-urethane和EGCG相关氢键,拓宽物理连接结合强度分布。

三、AUE水凝胶的机械和自愈合性能
1、机械性能
AUE-3水凝胶机械性能良好,如高拉伸性、拉伸强度和韧性。随着UPy含量增加,拉伸应力-应变曲线接近J-形曲线。过高UPy含量会降低韧性和拉伸性,AUE-3水凝胶表现出优化性能。与AHE-3水凝胶相比,AUE-3水凝胶因UPy形成的四重氢键交联,机械性能指标更高。

2、自愈合性能
AUE-3水凝胶切割后在60 °C不同恢复时间进行拉伸应力-应变测试,具有自愈合能力。愈合后的水凝胶在不同伸长率下可能失效,但仍保持一定机械强度,自愈合机制与内部动态可逆的多层次物理交联有关。

四、AUE水凝胶的粘附性能
1、组织粘附
通过对猪皮等组织的搭接剪切试验,AUE-3水凝胶粘附性能优异。随着UPy-基于片段含量变化,对猪皮即时剪切强度先增后减,在AUE-3水凝胶中达最高值263.2kPa。不含UPy的AHE-3水凝胶粘附强度远低于AUE水凝胶。

2、动态粘附
进行循环拉伸搭接剪切试验,将水凝胶夹在两片猪皮之间,在50%应变下测试。AUE-3水凝胶对猪皮有强且可重复的粘附性,经1000次循环变形后粘附性能无明显衰减,还可密封刺破气球针孔并承受反复放气-充气循环。

3、抗肿胀性能
AUE-3水凝胶抗肿胀性能良好。与AUE-1和AUE-2水凝胶相比,有稳定肿胀动力学,浸泡14天仍保持与原始状态相似肿胀面积,归因于烷基-基于疏水口袋和多种氢键簇自聚集。

五、AUE水凝胶的内部相互作用
通过多种手段研究AUE-3水凝胶内部结构和相互作用。
动态光散射(DLS)分析显示,AU前驱体溶液中随UPy含量增加出现峰值,对应疏水缔合和UPy-基于氢键簇形成,纯AAc水溶液为均匀溶液。
小角X射线散射(SAXS)测量表明,AUE-3和AU-3水凝胶存在纳米级微相分离结构,有两个散射峰对应不同氢键簇聚集区域。
X射线衍射(XRD)和差示扫描量热法(DSC)结果显示水凝胶呈无定形状态,玻璃化转变温度较高,如AUE-3水凝胶薄膜的Tg为122°C,因UPy-UPy强烈聚集。
温度可变的傅里叶变换红外光谱(FTIR)和二维相关光谱(2DCOS)分析揭示多种氢键在温度变化下的解离顺序,证明分层多强度氢键结构。
分子动力学(MD)模拟和X射线光电子能谱(XPS)研究表明AUE-3水凝胶内部分子间相互作用更强且氢键更多,为相分离辅助的分层多物理交联结构。

六、AUE-3水凝胶的体外生物相容性和体内性能
1、生物相容性
体外细胞培养实验中,AUE-3水凝胶和AU-3水凝胶孵育24小时和72小时后细胞相容性良好,细胞存活率高。溶血试验显示水凝胶提取物与生理盐水组相似,溶血率低于2%,血液相容性好。

2、体内止血性能
在大鼠肝脏创伤和切口模型中,AUE-3水凝胶止血能力优异。与对照组相比,应用AUE-3水凝胶后血液流失明显减少,在肝脏创伤模型中对照组血液损失为312±37.3 mg,AUE-3水凝胶组为35±7.6 mg;在肝脏切口模型中对照组血液损失为653±72.6 mg,AUE-3水凝胶组为50±8.7 mg,止血机制与水凝胶快速粘附能力和EGCG支持的血液凝固有关。

3、体内伤口闭合和愈合性能
在大鼠全层皮肤切口模型中,AUE-3水凝胶术后第1天快速闭合伤口,愈合过程中保持伤口闭合,抵抗皮肤拉伸力。与PBS处理和常规缝合相比,AUE-3水凝胶处理组伤口闭合率更高,术后7天达96%,缝合组为65%,PBS组为47%。组织学评估显示AUE-3水凝胶处理组表皮和真皮再生更完整,炎症反应更轻,胶原蛋白沉积更多,促进伤口愈合。

七、AUE-3水凝胶的抗氧化和抗菌性能
1、抗氧化能力
通过DPPH、ABTS和PTIO自由基清除试验评估抗氧化能力。AUE-3水凝胶抗氧化能力良好,如在DPPH自由基清除试验中,孵育5分钟后AUE-3水凝胶清除效率高达88.5±1.7%,而AU-3水凝胶仅为4.2±1.5%,归因于EGCG的存在。

2、抗菌性能
选择大肠杆菌和金黄色葡萄球菌进行抗菌试验。AUE-3水凝胶对这两种细菌抗菌活性良好,抗菌效率随水凝胶含量增加而提高,抗菌机制可能与EGCG释放有关,EGCG可能破坏细菌细胞壁抑制细菌生长。
八、结论
本研究制备的AUE超分子水凝胶利用分层多强度氢键铰链策略,实现了优异机械性能和强大粘附能力的平衡。具有高拉伸性、拉伸强度、韧性、即时且强大的组织粘附力、良好抗肿胀性能和抗氧化、抗菌等生物特性,在肝脏损伤止血和皮肤切口愈合中表现良好,有医学转化潜力,可作为止血和无缝合伤口闭合的自救组织粘附贴片。
九、一起来做做题吧
1、在组织修复领域,现有合成聚丙烯酸(PAAc)及其衍生物作为生物粘合剂的主要问题不包括以下哪项?
A.水下粘附性差
B.易漏液
C.平衡机械和粘附性能困难
D.抗菌性能强
2、AUE-3水凝胶中,对其机械性能起关键作用的结构不包括以下哪种氢键?
A.UPy-UPy(四重氢键)
B.COOH-COOH(双重氢键)
C.urethane-urethane(单一氢键)
D.EGCG-EGCG(单一氢键,与自身)
3、AUE-3水凝胶对猪皮的即时粘附强度最高可达多少?
A.21.8±3.9kPa
B.182.4±29.1kPa
C.263.2kPa
D.114.1±8.7kPa
4、本研究制备的AUE超分子水凝胶的主要优势不包括以下哪项?
A.高拉伸性
B.高溶胀性
C.良好的抗氧化性能
D.平衡的机械-粘附性能
参考文献:
Yang J, et al. A supramolecular hydrogel leveraging hierarchical multi-strength hydrogen-bonds hinged strategy achieving a striking adhesive-mechanical balance. Bioact Mater. 2024 Sep 17;43:32-47.
